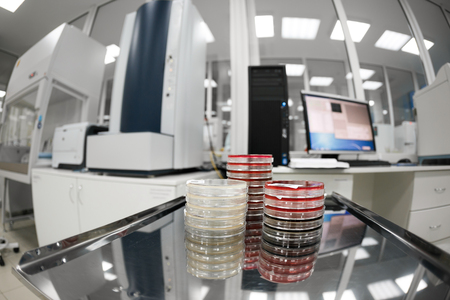
medical devices for analyzes. blood tested for AIDS and other diseases. definition of DNA. selective focusの写真素材

写真素材 - medical devices for analyzes. blood tested for AIDS and other diseases. definition of DNA. selective focus
作品情報
medical devices for analyzes. blood tested for AIDS and other diseases. definition of DNA. selective focus
- ID:75053069
- 作品種別:写真
- 作者名:Konstantin Malkov
キーワード
- AIDS
- DNA
- HIV
- analysis
- analyze
- analyzing
- biology
- biotechnology
- blood
- care
- chemical
- chemistry
- clinic
- computer
- device
- diabetes
- diagnostic
- equipment
- examination
- experiment
- health
- healthcare
- hospital
- illness
- industry
- instrument
- lab
- laboratory
- machine
- measurement
- medical
- medicine
- microscope
- modern
- monitor
- monitoring
- patient
- pharmaceutical
- professional
- research
- science
- scientific
- scientist
- technology
- test
- tool
- tube
- ultrasound
- white
類似作品
EKG monitor at ...
medicine and sy...
Package with do...
Blood glucose m...
tonometer. Meas...
young caucasian...
Concept of pets...
childbirth duri...
Surgical room w...
isolated hands ...
Flat lay compos...
Nurse adjusting...
World diabetes ...
World diabetes ...
giving packed r...
Beautician in t...
Diabetes suppli...
Syringe with bl...
Syringe with bl...
A top-down view...
Medical layout ...
Education about...
Instruments for...
Doctor checking...
Donors are dona...
Young woman mak...
Glucose meter, ...
medicine and ha...
medical stethos...
Doctor using sp...
various methods...
Hands of a medi...
antigen test ki...
Medical drug va...
Coronavirus med...
Disposable syri...
Modern fingerti...
Medicine online
Fetal heartbeat...
Reception at th...
A sterile medic...
Injection into ...
bag with blood ...
Equipment and d...
In a laboratory...
This infusion p...
Pulse oximeter ...
Dental instrume...
Doctor in latex...